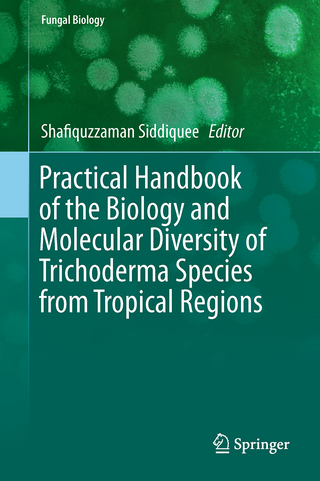
Practical Handbook of the Biology and Molecular Diversity of Trichoderma Species from Tropical Regions

eBook Download (EPUB)
2017
|
Auflage:
1
|
John Wiley & Sons
ISBN: 9781683673040
171,99 €
(CHF 167,95) (inkl. MwSt)
(CHF 167,95) (inkl. MwSt)
- Download sofort lieferbar